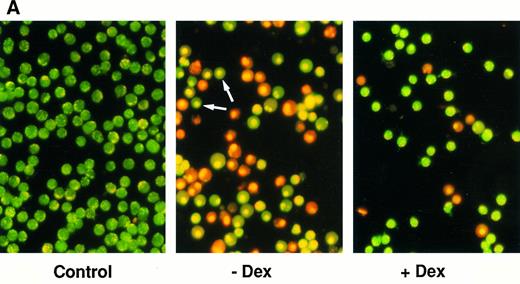
Fig. 4. Effect of calcium ionophore on the viability on FDC-P1 transfectants expressing or not expressing mcl-1. (A) Photographs of clone 7.5-MAMmcl-1 either left untreated (Control) or exposed to 1.5 μmol/L A23187 in the absence (−Dex) or presence of dexamethasone (+Dex), as assessed by the ethidium bromide/acridine orange method. Arrows indicate cells that have condensed nuclei but have not lost membrane integrity. Photographs were taken at a magnification of 400×. / (B) Clones 7.5-MAMmcl-1 and 8.5-MAMneo were either incubated (+) or not incubated (−) with dexamethasone for 2 hours at an inoculum density of 5 × 105 cells/mL. A23187 (1.5 μmol/L) was added and cell viability was was assayed at the indicated times using the ethidium bromide/acridine orange method. The values shown are the mean ± SD of three independent experiments.

Abstract
Mcl-1 is a member of the Bcl-2 family that was identified based on increased expression in myeloblastic leukemia cells undergoing differentiation. Mcl-1 was previously found to be similar to Bcl-2 in causing a delay in apoptotic cell death in Chinese hamster ovary cells. The work described here was aimed at determining whether Mcl-1 could also exert such an effect in hematopoietic cells, because endogenous Mcl-1 expression is prominent in the hematopoietic system. A further aim was to assess the effects of Mcl-1 in cells exposed to a variety of cytotoxic stimuli, because Bcl-2 is known to have a broad spectrum of activity. To approach these aims, FDC-P1 murine myeloid progenitor cells were transfected with vectors driving either constitutive or inducible expression of Mcl-1. The introduced Mcl-1 gene was found to cause a prolongation of viability under various conditions that cause apoptotic cell death, including exposure to cytotoxic agents (the chemotherapeutic drug etoposide, calcium ionophore, or UV irradiation) and the withdrawal of required growth factors. In addition, Mcl-1 was found to interact with Bax, a member of the Bcl-2 family that promotes cell death as a homodimer but that can heterodimerize with Bcl-2 to promote cell viability. Although Mcl-1 prolonged cell viability, it did not prevent eventual cell death upon continuous exposure to a cytotoxic agent. Prolongation of viability was maximal when expression of Mcl-1 was induced before the application of the apoptotic stimulus, although some increase occurred if Mcl-1 was induced shortly thereafter and before overt apoptosis. Taken as a whole, these findings provide further parallels between Mcl-1 and Bcl-2, showing that Mcl-1 can interact with Bax in hematopoietic FDC-P1 cells and can prolong cell viability under a variety of cytotoxic conditions.
A FAMILY OF bcl-2–related genes has emerged and is growing rapidly.1-4 We discovered mcl-1, one of the members of this family, during a screen for genes that increase in expression early in the differentiation of ML-1 human myeloblastic leukemia cells.3 In these cells, expression of mcl-1 increases within 1 to 3 hours after exposure to the differentiation-inducing agent 12-O-tetradecanoylphorbol 13-acetate (TPA).3,5 This increase in mcl-1 coincides with the commitment of ML-1 cells to differentiation and loss of proliferation without loss of viability.3,6 mcl-1 is also expressed in normal hematopoietic cells at early stages of differentiation.7
A hallmark of the members of the Bcl-2 family is their effects on cell viability. Bcl-2 itself can promote survival in a variety of cell types under many different conditions in which cell death is due to apoptosis.8,9 For example, Bcl-2 can prolong the survival of cells deprived of required growth factors or exposed to various cytotoxic agents such as chemotherapeutic drugs or radiation.8-19 Despite its pronounced effects on viability, Bcl-2 does not promote cell proliferation and can even retard it.8,9,20 Several other bcl-2 family members similarly promote cell viability (eg, bcl-xL ,1 the ced-9 gene from C elegans,21 and the viral Bhrfl gene22 ). Other family members, such as bax,23 have the opposite effect, accelerating cell death under apoptosis-inducing conditions. Bax:Bax homodimerization is thought to promote cell death, whereas the formation of Bcl-2:Bax heterodimers promotes cell viability.23 24
We previously found Mcl-1 to be similar to Bcl-2 in that Mcl-1 could prolong the viability of Chinese hamster ovary (CHO) cells undergoing apoptosis in response to c-myc overexpression.25 However, Mcl-1 appeared to be subtly different from Bcl-2 in that the delay in cell death produced by Mcl-1 was less pronounced than that produced by Bcl-2.25 Mcl-1 was also found to be similar to Bcl-2 in inhibiting Bax-induced death in a yeast cell system.26 In contrast, Mcl-1 has been reported to have a minimal effect on viability in 32D murine myeloid progenitor cells undergoing apoptosis in response to interleukin-3 (IL-3) deprivation.27 The minimal effect in these myeloid cells was puzzling in view of the fact that mcl-1 was originally isolated from a myeloid leukemia cell line and is normally expressed in hematopoietic and lymphoid tissues.7 28 Another puzzling finding was that, although Mcl-1 (like Bcl-2) could bind to Bax in the yeast two-hybrid system and in cell-free systems, Mcl-1 was not found to associate with Bax in intact 32D cells. These findings raised the question of whether Mcl-1 could affect cell viability in systems other than CHO and, more specifically, whether its function in hematopoietic cells related to enhancement of viability. The issue was also raised as to whether Mcl-1 could associate with Bax in intact hematopoietic cells as it can in the more artificial systems.
In characteristics other than effects on viability, Mcl-1 has also been found to exhibit similarities to, as well as some differences from, Bcl-2. For example, the two proteins exhibit overlapping but nonidentical intracellular distributions, differing in their relative distributions in mitochondria versus other intracellular membrane-containing compartments.5 Similarly, the turnover of the two proteins differs, with Mcl-1 being a rapidly turned over PEST protein, whereas Bcl-2 is quite stable (Yang et al5 and references therein). Finally, the two differ in their pattern of expression, with Mcl-1 increasing in the early stages of ML-1 differentiation, whereas Bcl-2 remains constant.5,29 Analogously, Mcl-1 and Bcl-2 are expressed at different stages of differentiation in many normal tissues (eg, in lymphoid tissues and complex epithelia), although their expression overlaps in some cases (eg, in immature cells in bone marrow7 28 ). The fact that Mcl-1 differs from Bcl-2 in several properties underscores the importance of gaining a clear understanding of its effects on cell viability, particularly in hematopoietic cells in which Mcl-1 expression is prominent.
To begin to investigate the function of Mcl-1 in hematopoietic cells, we used the murine FDC-P1 cell line, which is dependent on IL-3 for growth and viability. This and similar lines have been used in showing the effects of Bcl-2.8,9,30 FDC-P1 cells are myeloid in origin and thus are somewhat comparable to ML-1, which could not be used because it could not be transfected in a stable fashion. We transfected FDC-P1 cells with vectors driving either constitutive or inducible expression of Mcl-1. The advantage of the inducible system was that the presence or absence of Mcl-1 could be compared in the same transfectant clone, thus eliminating differences arising from clonal variation. We tested the response of these transfectants to a variety of different cytotoxic stimuli, our rationale being that Mcl-1 had been studied under only two types of apoptosis-inducing conditions (oncogene overexpression and growth factor deprivation25,27 ), whereas Bcl-2 is known to have broad effects. The types of conditions tested included growth factor deprivation as well as exposure to various agents that are known to cause cell death by apoptosis but that had not been tested with Mcl-1, such as the chemotherapeutic drug etoposide, calcium ionophore, and UV irradiation.9 31-34 In addition to assessing the effects of Mcl-1 on viability, we also tested for an association with Bax. The results of these studies showed that Mcl-1 could associate with Bax in hematopoietic FDC-P1 cells and could prolong cell viability under a variety of cytotoxic conditions.
MATERIALS AND METHODS
Cell culture.FDC-P1 cells were obtained from Dr W. Stratford May and 32D clone 3 cells were obtained from Dr Alan Friedman (both at Johns Hopkins School of Medicine, Baltimore, MD). These cells were maintained by incubation at 37°C (5% CO2 ) using standard medium, which consisted of RPMI 1640 medium (GIBCO [Grand Island, NY] or Paragon [Baltimore, MD]) supplemented with 25 mmol/L HEPES buffer, 0.0004% (vol/vol) β-mercaptoethanol, 10% fetal bovine serum (FBS; GIBCO), and 10% conditioned medium from WEHI-3b cells as a source of IL-3.35 The WEHI-3b cells were obtained from Dr Alan Friedman, with their conditioned medium35 being produced by culturing the cells in RPMI 1640 medium containing 1% FBS for 4 days, followed by sterile filtration of the medium.
Clonal transfectant lines derived from the FDC-P1 cells were maintained in transfectant growth medium (standard medium supplemented with 50 U/mL penicillin, 50 μg/mL streptomycin, and 0.4 mg/mL Geneticin [G-418; GIBCO]). For clones transfected with vectors using the promoter of the mouse mammary tumor virus long terminal repeat (MAM-LTR; see below), phenol red-free RPMI 1640 (GIBCO) was used.
Plasmid construction.The pCMVmcl-1 plasmid was constructed to allow constitutive expression of Mcl-1 and has been used previously.25 Briefly, a cDNA clone containing the entire mcl-1 coding region (p3.2, containing nucleotides 7-1479 of the mcl-1 cDNA in Bluescript3 ) was digested with EcoRI to obtain the mcl-1 insert, which was made blunt-ended. The mammalian expression vector pCMVneo36 (obtained from Dr B. Vogelstein, Johns Hopkins School of Medicine, Baltimore, MD) was digested with BamHI and made blunt-ended. The mcl-1 cDNA insert was then ligated into pCMVneo and a plasmid containing mcl-1 in the sense orientation was selected and named pCMVmcl-1. In this vector, mcl-1 is under the control of the cytomegalovirus (CMV) early region promoter/enhancer and is on the same plasmid as the neoR gene conferring resistance to G-418.
To obtain inducible expression of Mcl-1, a pMAMmcl-1 plasmid was constructed as follows. A cDNA clone containing the entire mcl-1 coding region (pλ5 containing nucleotides 33-1479 of the mcl-1 cDNA in Bluescript3 ) was digested with Sal I and Xba I. The Mcl-1 insert was then directionally cloned into the pMAMneo vector (Clontech, Palo Alto, CA), which had been digested with Sal I and Nhe I. In this context, Mcl-1 is under the control of the MMTV-LTR and is on the same plasmid as the neoR gene. The above-mentioned vectors and the control plasmids lacking the Mcl-1 insert were purified using Qiagen columns.
Electroporation and cloning of transfectants.On the day before electroporation, FDC-P1 cells were diluted to 2 × 105 cells/mL using standard medium. The following day, cells were washed twice with and resuspended in ice-cold Dulbecco's phosphate-buffered saline (PBS; Paragon) at 107 cells/mL. Plasmid DNA was linearized at the HindIII site for pCMV-based vectors and at the Nde I site for pMAM-based vectors. The DNA (10 μg) was then added to 0.5 mL of the cell suspension, followed by incubation for 10 minutes on ice. Electroporation was performed on a Genepulser (Bio-Rad, Hercules, CA) using settings of 250 V and 500 μF. Electroporated cells were incubated on ice for 10 minutes and then at 37°C (at 5 × 105 cells/mL) in enriched medium, which consisted of RPMI 1640 supplemented with 20% FBS, 20% WEHI-3b conditioned medium, penicillin, streptomycin, and β-mercaptoethanol as described above. After 2 days, G-418 was added to a final concentration of 0.4 mg/mL. After 4 to 6 days, transfectants were subjected to limiting dilution in 96-well plates (∼1 viable cell/mL) using a mixture of enriched medium (50%) and filtered conditioned medium from parental FDC-P1 cells (50%), with the concentration of G-418 being maintained at 0.4 mg/mL. In initial trial electroporations (not described here), no neoR FDC-P1 clones were obtained. It was only after developing the protocol detailed here, in which enriched medium was used and cloning was delayed for 4 to 6 days after electroporation, that stable transfectants were obtained.
Western blotting.Cells to be tested for expression of the introduced Mcl-1 protein were washed in PBS and then lysed by resuspension in hypotonic buffer (10 mmol/L HEPES, pH 7.0, 5 mmol/L KCl, and 2 mmol/L MgCl2 ), followed by the addition of sample buffer (to a final 1× concentration of 62.5 mmol/L Tris-Cl, pH 6.8, 1% sodium docecyl sulfate [SDS], 1% β-mercaptoethanol, 10% glycerol, and 0.5% bromphenol blue) and boiling for 5 minutes. Protein concentration was measured using the DC protein assay kit (Bio-Rad) and the lysates were subjected to SDS-polyacrylamide gel electrophoresis (SDS-PAGE; 12%), followed by transfer (130 V for 1 hour) to Immobilon-P membranes (Millipore, Bedford, MA). These membranes were incubated for 1 hour with 5% nonfat dry milk (Carnation, Glendale, CA) in PBS. They were then incubated for 1 hour with a polyclonal rabbit anti–Mcl-1 antibody, which has been described elsewhere.5 The antibody was either an affinity-purified preparation (purified on an affinity column prepared using the Mcl-1–GST fusion protein) or the IgG fraction obtained from a protein A column (Pierce, Rockford, IL). The affinity purified antibody was used at a 1:50 dilution in 5% bovine serum albumin (BSA; in PBS) and the IgG fraction was used at a 1:500 to 1:1,000 dilution in 5% BSA (in PBS). The antibody specifically recognizes the human Mcl-1 protein,5 but does not detect specific murine Mcl-1 bands in FDC-P1 cells. After incubation with the primary antibody, the membranes were washed three times (5 minutes each) with PBS. They were then incubated for 1 hour with horseradish peroxidase (HRP)-conjugated goat antirabbit IgG (Pierce) that had been diluted 1:1,500 with 5% BSA (in PBS). The membranes were again washed three times with PBS and developed using enhanced chemiluminescence (Amersham, Arlington Heights, IL). In some cases, autoradiographs were subjected to scanning densitometry using a densitometer from E-C Apparatus Corp (St Petersburg, FL). Immunoblotting for the endogenous Bcl-2 protein was performed similarly, except that the primary antibody was a monoclonal hamster antimouse Bcl-2 antibody (Pharmingen, San Diego, CA) and the secondary antibody was HRP-conjugated goat antihamster IgG (Jackson Immunoresearch Laboratory, West Grove, PA). In some cases, an anti–Bcl-2 antibody that detects both human and mouse Bcl-2 (Santa Cruz Biotechnology, Santa Cruz, CA) was used.
Assay for coimmunoprecipitation of Bax with Mcl-1.The association of Mcl-1 (or Bcl-2 as a positive control) with Bax was assessed by immunoprecipitation with the anti–Mcl-1 antibody5 (or the anti–Bcl-2 antibody from Pharmingen), followed by Western blotting of the immunoprecipitates using an anti-Bax antibody. This was accomplished by collecting cells by centrifugation, washing them once with cold PBS, and resuspending them (2 × 107 cells/mL) in a buffer consisting of 50 mmol/L HEPES, pH 7.2, 150 mmol/L NaCl, 0.2% NP-40, 2 mmol/L EGTA, and 2 mmol/L EDTA and containing 1 mmol/L phenylmethylsulfonyl fluoride (PMSF ), 10 μg/mL aprotinin, 1 μg/mL leupeptin, and 1 μg/mL pepstatin A. The cells were then lysed by gentle shaking at 4°C for 30 minutes. After centrifugation at 14,000g for 10 minutes (4°C), the supernatant was incubated for 2 hours (with gentle shaking) with the anti–Mcl-1 antibody,5 which had been coupled to protein A sepharose beads as described.37 When the anti–Bcl-2 antibody (which was not coupled to beads) was used instead of the anti–Mcl-1 antibody, the supernatant was first incubated with the antibody for 1 hour, at which time protein A Sepharose beads were added for 1 additional hour. The immunoprecipitates were recovered (3,000g), washed three times with the above-mentioned lysis buffer, and solubilized in 1× sample buffer. The samples were then subjected to electrophoresis and transferred to membranes as described above. Western blotting was performed using an anti-Bax rabbit polyclonal antibody that had been raised against a peptide representing amino acids 11 to 30 of human Bax, which is identical to the corresponding domain of mouse Bax (Santa Cruz Biotechnology; diluted 1:500). For confirmation of specificity, an aliquot of the anti-Bax antibody was used after preincubation for 2 hours (room temperature) with the peptide against which the antibody had been generated, with the concentration of the peptide (by weight) being 10-fold higher than that of the antibody.
Analysis of effects of Mcl-1 on cell death.To assess the effects of exposure to etoposide, a stock of 10 mg/mL etoposide (Sigma, St Louis, MO) in dimethylsulfoxide (DMSO) was diluted to the appropriate concentration in tissue culture medium. In experiments in which viability was assessed after etoposide removal, cells were collected by centrifugation, washed twice with RPMI 1640, and then resuspended in drug-free medium. For exposure to calcium ionophore, a stock of 1 mmol/L A23187 (Sigma) in DMSO was diluted to the appropriate concentration in tissue culture medium. For exposure to UV irradiation, cells were placed at a distance of 66 to 67 cm from the UV source (the UV light in a Baker [Sanford, ME] Sterilgard tissue culture hood) and exposed to an intensity of 40 μW/cm2 for 2.5 to 3 minutes (60 to 72 J/m2).
When clones transfected with pMAMmcl-1 vector were exposed to the above-mentioned agents, cell death was assayed in the presence or absence of dexamethasone. Dexamethasone (Sigma; 1 mmol/L stock in ethanol) was used at a concentration of 0.1 μmol/L and was applied 2 hours before the application of the cytotoxic stimulus, except in preliminary experiments and in Fig 3B, in which a variety of different concentrations and times of dexamethasone addition were tested.
Effect of the timing of etoposide application and of mcl-1 induction on the viability of FDC-P1 transfectants. (A) Effect of short-term exposure to etoposide. Cells were treated as in Fig 2A, except that etoposide (20 μg/mL) was washed out after the indicated times and replaced with drug-free medium. For samples exposed to dexamethasone, dexamethasone was again added to the medium after drug wash-out. Cell viability was assayed at 24 hours; thus, the point indicating 24 hours of exposure to etoposide represents continuous exposure. In separate experiments, cells exposed to etoposide for 0.5 hours were observed for 3 days. Cell viability in clone 8.5-MAMneo (with or without dexamethasone) and clone 7.5-MAMmcl-1 (without dexamethasone) averaged 78% to 83% on day 1 and 57% to 65% on days 2 and 3. These values for clone 7.5-MAMmcl-1 (with dexamethasone) averaged 95% on day 1 and 79% to 81% on days 2 and 3. (B) Effect of expression of mcl-1 after exposure to etoposide. Cells were treated essentially as in Fig 2A, except that dexamethasone was added at various times either before, concomitant with, or after the time of addition of etoposide (20 μg/mL). The inoculum density was 5 × 105 cells/mL. Cell viability was assayed at the 24-hour time point. The time point labeled “0” indicates concomitant addition of dexamethasone and etoposide. The point labeled “−2” indicates addition of dexamethasone 2 hours before the addition of etoposide. For both (A) and (B), the values shown are the mean ± SD of three independent experiments. Where no bars are seen, the SD fell within the symbol.
Effect of the timing of etoposide application and of mcl-1 induction on the viability of FDC-P1 transfectants. (A) Effect of short-term exposure to etoposide. Cells were treated as in Fig 2A, except that etoposide (20 μg/mL) was washed out after the indicated times and replaced with drug-free medium. For samples exposed to dexamethasone, dexamethasone was again added to the medium after drug wash-out. Cell viability was assayed at 24 hours; thus, the point indicating 24 hours of exposure to etoposide represents continuous exposure. In separate experiments, cells exposed to etoposide for 0.5 hours were observed for 3 days. Cell viability in clone 8.5-MAMneo (with or without dexamethasone) and clone 7.5-MAMmcl-1 (without dexamethasone) averaged 78% to 83% on day 1 and 57% to 65% on days 2 and 3. These values for clone 7.5-MAMmcl-1 (with dexamethasone) averaged 95% on day 1 and 79% to 81% on days 2 and 3. (B) Effect of expression of mcl-1 after exposure to etoposide. Cells were treated essentially as in Fig 2A, except that dexamethasone was added at various times either before, concomitant with, or after the time of addition of etoposide (20 μg/mL). The inoculum density was 5 × 105 cells/mL. Cell viability was assayed at the 24-hour time point. The time point labeled “0” indicates concomitant addition of dexamethasone and etoposide. The point labeled “−2” indicates addition of dexamethasone 2 hours before the addition of etoposide. For both (A) and (B), the values shown are the mean ± SD of three independent experiments. Where no bars are seen, the SD fell within the symbol.
To assess the effects of growth factor withdrawal, clones growing logarithmically in transfectant growth medium were washed three times with RPMI 1640 (serum-free) and transferred to growth factor-depleted medium. Growth factor-depleted medium differed from transfectant growth medium in that it lacked WEHI-3b conditioned medium and contained only 1% FBS, with all other constituents being identical.
Cell number was assayed by Coulter counter or hemacytometer (Coulter, Opa Locka, FL). Cell viability was assayed using either trypan blue dye exclusion6 or by an acridine orange/ethidium bromide fluorescent staining method that allows one to assess cell death by apoptosis.38 Apoptotic cell death was originally defined by morphologic criteria.39 In tissue culture, cells dying by apoptosis generally pass progressively through the following phases as assessed morphologically: cell shrinkage with nuclear condensation (phase I) and cell surface membrane blebbing with nuclear crenation or fragmentation (phase II), followed by cell membrane rupture and progressive degeneration of nuclear and cytoplasmic structures (phase III).40 The acridine orange/ethidium bromide method allows one to discriminate cells in phases I or II (nuclear condensation/fragmentation without loss of membrane integrity) from those in phase III. This method works as follows. The acridine orange binds to DNA providing fluorescent labeling of the cell nucleus; this allows one to determine whether the nucleus has become apoptotic (condensed or fragmented with dense staining) or retains the normal nonapoptotic appearance seen in viable control cells (open/lacy architecture and staining pattern). Acridine orange is taken up by all cells and thus does not distinguish cells that retain membrane integrity from those that do not. The concomitant use of ethidium bromide allows one to make this distinction, because ethidium bromide is taken up exclusively by cells that have lost membrane integrity. Thus, cells that retain membrane integrity take up only acridine orange, which stains the nuclei bright green. Cells that have lost membrane integrity additionally take up ethidium bromide, which causes the nuclei to stain bright orange instead of bright green. In sum, cells in which the nuclei are stained green have not lost membrane integrity; among these, one can distinguish apoptotic from nonapoptotic cells based on the presence or absence, respectively, of nuclear condensation/fragmentation. In contrast, cells in which the nuclei are stained orange have lost membrane integrity. In principle, these latter cells can also be segregated as being either apoptotic or nonapoptotic, based on nuclear condensation/fragmentation. In the experiments described here, we did not observe significant numbers of cells that had lost membrane integrity but had nonapoptotic nuclei (cells dying by necrosis), probably because we used agents well known to cause cell death by apoptosis. Therefore, in practice, three categories of cells were present: cells with nuclei that stained green and were nonapoptotic (unchanged viable cells), cells with nuclei that stained green and were apoptotic (condensed/fragmented; apoptosis phase I/II), and cells with nuclei that stained orange and were apoptotic (apoptosis phase III). The acridine orange/ethidium bromide assay was performed as follows. Two microliters of dye mix (100 μg/mL each of acridine orange and ethidium bromide) was added to 25 μL of cell suspension. Cell populations were scored according to the three categories described above using a UV fluorescence microscope (Nikon, Garden City, NY) and counting at least 200 cells for each sample. Another DNA staining fluorescent dye, 4′,6-diamidino-2-phenylindole (DAPI; Sigma) was used in some experiments in which photographs were desired. For this method, cells were incubated for 5 minutes at room temperature with DAPI at a final concentration of 1 μg/mL in PBS. Cells were then mounted with mounting medium and photographed using a Zeiss Axiophot microscope equipped with a camera (Carl Zeiss, Thornwood, NY).
RESULTS
Expression of Mcl-1 in FDC-P1 transfectants and its binding to Bax.We generated two sets of clonal FDC-P1 cell lines transfected with mcl-1, Mcl-1 being expressed in an inducible fashion in one set and constitutively in the other. In the first set, designated the MAMmcl-1 clones, mcl-1 was under the control of the MMTV-LTR, which allows induction of expression by dexamethasone. In the second set, designated the CMVmcl-1 clones, Mcl-1 was under the control of the CMV promoter that confers constitutive expression. Control clones were obtained by transfection with vectors lacking the mcl-1 insert and were designated the MAMneo and CMVneo clones. All of these clones were derived by selection in G-418 and limiting dilution, as described in the Materials and Methods. We note that parallel transfections were performed using 32D cells. Although identical vectors were used, the levels of Mcl-1 expression achieved in FDC-P1 cells (see below) were higher than those obtained in 32D cells. Thus, although we observed effects similar to those published by others using 32D (ie, minimal effects on viability27 ), we could not rule out the possibility that this was simply due to low levels of expression of the transfected mcl-1 gene product. For this reason, we focused our studies on the FDC-P1 transfectants, as described below.
Expression of the introduced mcl-1 gene product in FDC-P1 transfectants. FDC-P1 clones transfected with either the inducible pMAMmcl-1 vector (A and C), the constitutively expressing pCMVmcl-1 vector (B and D), or appropriate control vectors (no mcl-1 insert) were assayed for expression of the introduced Mcl-1 gene product (A, B, and D) or expression of bcl-2 (B) by Western blot. (A) mcl-1 transfectant 7.5-MAMmcl-1 (lanes 1 through 4) and vector-only clone 8.5-MAMneo (lanes 5 and 6) were either exposed (+) or not exposed (−) to dexamethasone and assayed at 2 hours. Lysate from TPA-induced ML-1 cells (5 × 10−10 mol/L TPA for 3 hours) was included on the blot for comparative purposes (lane 7). Each lane contains 40 μg of protein. Either preimmune serum (lane 1, Pre.) or anti–mcl-1 immune serum (affinity-purified, lanes 2 through 7) was used. In lane 3, the immune serum had been blocked (Bl.) with bacterially produced mcl-1–GST fusion protein. (B) mcl-1 transfectants S3-CMVmcl-1 and S8-CMVmcl-1 and vector-only clones V1-CMVneo and V2-CMVneo were assayed for expression of Mcl-1 as in (A), except that an IgG fraction of the anti–mcl-1 antiserum was used. The lysate in lanes 1 through 4 represents 2 × 106 cell equivalents and that in lane 5 represents 2 × 105 cell equivalents. The numbers on the left indicate molecular weight markers (in kilodaltons). (C) The transfectant clones shown in (A) were assayed for expression of the endogenous mouse bcl-2 gene produce. Each lane represent 1 × 106 cell equivalents. (D) The S3-CMVmcl-1 transfectant was used for immunoprecipitation of either mcl-1 (lanes 1 and 4; 8 × 106 cell equivalents per lane) or bcl-2 (lane 2). Lane 3 contains lysate (no immunoprecipitation) from TPA-treated ML-1 cells (106 cells as in [A], lane 7), which had previously been found to express abundant levels of Bax. After immunoprecipitation, Western blotting was performed using an anti-bax antibody (lanes 1 through 3) or the anti-bax antibody after preincubation with the peptide against which the antibody had been generated. (E) The transfectant clones shown in (B) were assayed for expression of the introduced Mcl-1 gene product after exposure for 1 day to 20 μg/mL etoposide (lanes 1 through 3) or after incubation for 3 days to medium lacking IL-3 and FBS (lanes 5 through 7). The number of cell equivalents loaded was 4 × 106 in lanes 1 through 3 and 2 × 106 in lanes 5 through 7. ML-1 cells treated with TPA (5 × 10−10 mol/L for 3 hours) were included on the blot as a positive control (2 × 105 cell equivalents; lanes 4 and 8).
Expression of the introduced mcl-1 gene product in FDC-P1 transfectants. FDC-P1 clones transfected with either the inducible pMAMmcl-1 vector (A and C), the constitutively expressing pCMVmcl-1 vector (B and D), or appropriate control vectors (no mcl-1 insert) were assayed for expression of the introduced Mcl-1 gene product (A, B, and D) or expression of bcl-2 (B) by Western blot. (A) mcl-1 transfectant 7.5-MAMmcl-1 (lanes 1 through 4) and vector-only clone 8.5-MAMneo (lanes 5 and 6) were either exposed (+) or not exposed (−) to dexamethasone and assayed at 2 hours. Lysate from TPA-induced ML-1 cells (5 × 10−10 mol/L TPA for 3 hours) was included on the blot for comparative purposes (lane 7). Each lane contains 40 μg of protein. Either preimmune serum (lane 1, Pre.) or anti–mcl-1 immune serum (affinity-purified, lanes 2 through 7) was used. In lane 3, the immune serum had been blocked (Bl.) with bacterially produced mcl-1–GST fusion protein. (B) mcl-1 transfectants S3-CMVmcl-1 and S8-CMVmcl-1 and vector-only clones V1-CMVneo and V2-CMVneo were assayed for expression of Mcl-1 as in (A), except that an IgG fraction of the anti–mcl-1 antiserum was used. The lysate in lanes 1 through 4 represents 2 × 106 cell equivalents and that in lane 5 represents 2 × 105 cell equivalents. The numbers on the left indicate molecular weight markers (in kilodaltons). (C) The transfectant clones shown in (A) were assayed for expression of the endogenous mouse bcl-2 gene produce. Each lane represent 1 × 106 cell equivalents. (D) The S3-CMVmcl-1 transfectant was used for immunoprecipitation of either mcl-1 (lanes 1 and 4; 8 × 106 cell equivalents per lane) or bcl-2 (lane 2). Lane 3 contains lysate (no immunoprecipitation) from TPA-treated ML-1 cells (106 cells as in [A], lane 7), which had previously been found to express abundant levels of Bax. After immunoprecipitation, Western blotting was performed using an anti-bax antibody (lanes 1 through 3) or the anti-bax antibody after preincubation with the peptide against which the antibody had been generated. (E) The transfectant clones shown in (B) were assayed for expression of the introduced Mcl-1 gene product after exposure for 1 day to 20 μg/mL etoposide (lanes 1 through 3) or after incubation for 3 days to medium lacking IL-3 and FBS (lanes 5 through 7). The number of cell equivalents loaded was 4 × 106 in lanes 1 through 3 and 2 × 106 in lanes 5 through 7. ML-1 cells treated with TPA (5 × 10−10 mol/L for 3 hours) were included on the blot as a positive control (2 × 105 cell equivalents; lanes 4 and 8).
Effect of etoposide on the viability of FDC-P1 transfectants expressing or not expressing mcl-1. (A) Effect of continuous exposure to etoposide for increasing times. The 7.5-MAMmcl-1 transfectant (circles) and the 8.5-MAMneo vector-only clone (squares) were either exposed (solid symbols) or not exposed (open symbols) to dexamethasone for 2 hours at an inoculum density of 6 × 105 cells/mL. Etoposide was then applied at 20 μg/mL (time 0). Cell viability was assayed at 1, 2, and 3 days using the ethidium bromide/acridine orange method. This experiment was also performed with clones expressing mcl-1 constitutively. When clones S3- and S8-CMVmcl-1 were exposed to etoposide for 1 day, cell viability was 73% ± 14% (SD; n = 3 independent experiments) and 62% ± 13%, respectively, compared with a value of 37% ± 12% in vector-only clone V5-CMVneo. Upon exposure for 2 days, these values were 43% ± 15%, 33% ± 12%, and 17% ± 6% for S3-CMVmcl-1, S8-CMVmcl-1, and V5-CMVneo, respectively, and with exposure for 3 days the values were 29% ± 6%, 31% ± 10%, and 12% ± 3%. (B) Effect of various concentrations of etoposide. Cells were treated as in (A), except that various concentrations of etoposide were applied for 1 day. Of the nonviable cells in cultures treated for with 20 μg/mL etoposide, the fraction of cells in phases I or II of apoptosis (as a percentage of the total dead cells) was 72% ± 9.8% and 73% ± 9.7% in clone 7.5-MAMmcl-1 in the absence and presence of dexamethasone, respectively (n = 6, 3 values from the experiments shown in [A] and 3 values from the experiments shown in [B]). These values were 62% ± 5.7% and 63% ± 9.3% for clone 8.5-MAMneo in the absence and presence of dexamethasone, respectively. For both (A) and (B), the values shown are the mean ± SD of three independent experiments.
(C) Illustration of the effects of etoposide. The vector-only 8.5-MAMneo clone (left photograph) and the 7.5MAMmcl-1 transfectant (right photograph) were exposed to dexamethasone and etoposide as in (A). Cells were stained after 1 day with DAPI. The vector-only clone contains cells with condensing or fragmenting nuclei, whereas the mcl-1 transfectant contains cells with the open/lacy nuclear architecture and staining pattern typical of viable control cells. Photographs were taken at a magnification of 1,250×.
Effect of etoposide on the viability of FDC-P1 transfectants expressing or not expressing mcl-1. (A) Effect of continuous exposure to etoposide for increasing times. The 7.5-MAMmcl-1 transfectant (circles) and the 8.5-MAMneo vector-only clone (squares) were either exposed (solid symbols) or not exposed (open symbols) to dexamethasone for 2 hours at an inoculum density of 6 × 105 cells/mL. Etoposide was then applied at 20 μg/mL (time 0). Cell viability was assayed at 1, 2, and 3 days using the ethidium bromide/acridine orange method. This experiment was also performed with clones expressing mcl-1 constitutively. When clones S3- and S8-CMVmcl-1 were exposed to etoposide for 1 day, cell viability was 73% ± 14% (SD; n = 3 independent experiments) and 62% ± 13%, respectively, compared with a value of 37% ± 12% in vector-only clone V5-CMVneo. Upon exposure for 2 days, these values were 43% ± 15%, 33% ± 12%, and 17% ± 6% for S3-CMVmcl-1, S8-CMVmcl-1, and V5-CMVneo, respectively, and with exposure for 3 days the values were 29% ± 6%, 31% ± 10%, and 12% ± 3%. (B) Effect of various concentrations of etoposide. Cells were treated as in (A), except that various concentrations of etoposide were applied for 1 day. Of the nonviable cells in cultures treated for with 20 μg/mL etoposide, the fraction of cells in phases I or II of apoptosis (as a percentage of the total dead cells) was 72% ± 9.8% and 73% ± 9.7% in clone 7.5-MAMmcl-1 in the absence and presence of dexamethasone, respectively (n = 6, 3 values from the experiments shown in [A] and 3 values from the experiments shown in [B]). These values were 62% ± 5.7% and 63% ± 9.3% for clone 8.5-MAMneo in the absence and presence of dexamethasone, respectively. For both (A) and (B), the values shown are the mean ± SD of three independent experiments.
(C) Illustration of the effects of etoposide. The vector-only 8.5-MAMneo clone (left photograph) and the 7.5MAMmcl-1 transfectant (right photograph) were exposed to dexamethasone and etoposide as in (A). Cells were stained after 1 day with DAPI. The vector-only clone contains cells with condensing or fragmenting nuclei, whereas the mcl-1 transfectant contains cells with the open/lacy nuclear architecture and staining pattern typical of viable control cells. Photographs were taken at a magnification of 1,250×.
We first screened FDC-P1 transfectant clones for the protein product of the introduced mcl-1 gene. The mcl-1 gene product (derived from a human mcl-1 cDNA3 ) was readily discernible, because our antibody did not detect specific cross-reacting bands in murine FDC-P1 cells. Thus, in clone 7.5-MAMmcl-1 transfected with the inducible vector, the Mcl-1 protein (molecular weight ∼40 to 42 kD5 ) was detectable in the presence but not the absence of dexamethasone, specificity being shown both by blocking with bacterially produced Mcl-1 and by the use of preimmune serum (Fig 1A). Expression of Mcl-1 in the presence of dexamethasone was equivalent to ∼25% of that seen in ML-1 cells induced to express high levels of Mcl-1 in response to TPA (generally a 7- to 15-fold increase is seen with TPA3,29). As expected, Mcl-1 was expressed constitutively in clones transfected with the pCMVmcl-1 vector (Fig 1B). FDC-P1 clones were also monitored for expression of Bcl-2, which was not found to be altered appreciably by the conditions used to induce expression of Mcl-1 (Fig 1C).
In further experiments, we monitored the timing of induction of Mcl-1 by dexamethasone. We found Mcl-1 protein levels to reach a maximum within 2 hours after the addition of 0.1 μmol/L dexamethasone; these levels were not further increased by increasing the concentration of dexamethasone to 0.25 μmol/L (data not shown). Therefore, in the experiments described below, a concentration of dexamethasone of 0.1 μmol/L was used and was added 2 hours before other experimental manipulations, unless otherwise specified. With this protocol, Mcl-1 levels were found to be slightly decreased 1 day after the addition of dexamethasone. Thus, for experiments with a duration of more than 1 day, the culture medium was resupplemented each day with additional dexamethasone (0.1 μmol/L). This regimen produced no slowing of growth and no cell death when standard phenol red-free medium was used. Phenol red-free medium was required because, when phenol red-containing medium was tested on the MAMmcl-1 clones, Mcl-1 could be faintly detected in the absence of dexamethasone (at a level of ∼6% of that seen in the presence of dexamethasone).
Because the protein product of the introduced mcl-1 gene was readily detectable in FDC-P1 cells, we next tested whether it could associate with Bax. Using a transfectant clone, we performed immunoprecipitation for Mcl-1 (or Bcl-2 as a positive control) and then subjected the immunoprecipitates to Western blotting for the detection of Bax. As expected, we observed coimmunoprecipitation of Bax with Bcl-2 (Fig 1D, lane 2). We also observed coimmunoprecipitation of Bax with the transfected mcl-1 gene product (Fig 1D, lane 1), although somewhat less Bax coimmunoprecipitated with Mcl-1 than with Bcl-2. The specificity of detection of Bax was confirmed by peptide inhibition (Fig 1D, lane 4). Thus, Mcl-1 was capable of interacting with Bax in hematopoietic FDC-P1 cells, confirming the significance of the interaction observed in more artificial systems such as the yeast two-hybrid system.27 41
Delay of cell death in mcl-1 transfectants exposed to the chemotherapeutic agent etoposide.Having transfected mcl-1 into FDC-P1 cells and having observed that it associates with Bax, we next set out to test for effects on cell viability. To this end, we incubated the 7.5-MAMmcl-1 transfectant and the vector-only 8.5-MAMneo clone as a control in the presence or absence of dexamethasone. We then followed the time course of the response of these cell lines to the chemotherapeutic drug etoposide, which inhibits topoisomerase II. The reason for testing this drug first was that it is known to cause cell death by apoptosis and this effect has been thoroughly documented in myeloid cells.31,42 43 We found continuous exposure to etoposide to cause cell viability to decrease rapidly in the absence of induction of Mcl-1; this decrease was retarded in cells induced by dexamethasone to express Mcl-1 (Fig 2A). Thus, on day 1, approximately 25% of cells were viable in uninduced cultures of clone 7.5MAMmcl-1, as compared with a value of ∼60% in cultures induced to express Mcl-1. The viability of the vector-only clone, in the presence or absence of dexamethasone, was essentially identical to that of the mcl-1 transfectant in the absence of dexamethasone. Photographs of etoposide-induced apoptosis in the vector-only clone, as contrasted with its inhibition in the mcl-1 transfectant, are shown in Fig 2C. In cultures induced to express Mcl-1, cell death on day 2 was approximately equivalent to the value seen on day 1 in control cultures. Thus, with continuous exposure to etoposide, cultures induced to express Mcl-1 required twice as much time as controls to reach a similar level of cell death. Transfectants expressing Mcl-1 constitutively also exhibited decreased cell death in response to etoposide (Fig 2A legend). In agreement with the delay in cell death, etoposide was not seen to cause a loss of expression of the introduced mcl-1 gene (Fig 1E).
Having examined the time course of effects of Mcl-1 on etoposide-induced cell death, we next performed a dose-response curve using a series of concentrations of etoposide (Fig 2B). At every concentration tested, cell viability was enhanced in cultures induced to express Mcl-1, with these cultures requiring an ∼10-fold increase in etoposide concentration to decrease cell viability to the control level. In both the time course and dose-response experiments (Fig 2A and B), cells in phases I/II of apoptosis (exhibiting nuclear condensation/fragmentation without loss of membrane integrity) could be distinguished from those in phase III (with secondary loss of membrane integrity; see the Materials and Methods). Although Mcl-1 caused a decrease in the percentage of dead cells, it did not cause a change in the relative proportions of cells in phases I/II versus phase III. Thus, the proportion of cells in phases I/II was 66% to 73% on day 1 and 31% to 41% on days 2 to 3 in clones 7.5MAMmcl-1 and 8.5MAMneo, both in the presence and absence of dexamethasone. These findings suggest that Mcl-1 decreases the proportion of cells entering the apoptotic death pathway but that, once this process is initiated, Mcl-1 does not affect the secondary loss of membrane integrity that marks the transition from phases I/II to phase III. In contrast to these effects seen in cells exposed to etoposide, Mcl-1 had little effect on the growth or viability of cells maintained in standard medium and not exposed to the drug (data not shown). The fact that mcl-1 promoted cell viability but not cell growth is typical of the viability-promoting members of the bcl-2 gene family.9
In the above-mentioned experiments, the protection from cell death by Mcl-1 appeared to be partial rather than complete in the sense that mcl-1 transfectants eventually died upon continuous exposure to the drug, with some transfectants dying within 1 day and others within 3 days (Fig 2A). However, it was not clear whether the partial protection observed was a property of Mcl-1 itself or whether it resulted from the use of continuous exposure to etoposide. Moreover, Western blotting had been used to confirm the continued presence of the transfected mcl-1 gene product in cells exposed to etoposide (Fig 1E). However, because Western blotting does not monitor expression in individual cells, it was not clear whether differences in Mcl-1 levels might account for the fact that some transfected cells died at earlier and others at later time points. In past experiments, we have monitored Mcl-1 in individual cells (see Fig 3A and B in Yang et al5 ). However, although we observed Mcl-1 expression to decrease in dying cells, it was not clear whether this decrease caused cell death or, conversely, was a consequence of cell death. Thus, in the present experiments, it would similarly have been difficult to determine whether heterogeneity in Mcl-1 levels accounted for the progressive death of transfectants from days 1 to 3. Nonetheless, we could readily determine whether the progressive death was due to the continuous drug exposure, because a short pulse of etoposide exposure is generally sufficient to cause apoptosis.31,42 Thus, we could apply etoposide for a brief pulse and monitor whether cells continued to die or whether Mcl-1 was capable of providing more complete protection from cell death. If Mcl-1 were capable of providing complete protection but this effect had been masked by continuous exposure to etoposide, then cells induced with dexamethasone might be expected to remain viable after a pulse exposure to etoposide while control cells died. Accordingly, we exposed cells to etoposide for various periods of time (0.5 to 24 hours followed by drug wash-out), in either the absence or the continuous presence of dexamethasone, and assayed viability at the final (24 hours) time point. We found that, even with a shortened duration of exposure to etoposide, some death occurred in cells cultured in dexamethasone, although a fourfold to sixfold increase in the etoposide exposure time was required to produce cell death equivalent to that seen in the absence of dexamethasone (Fig 3A). We further monitored cell death 2 to 3 days after the 0.5-hour etoposide exposure time. We found that, even this very brief pulse of etoposide exposure was sufficient to cause some cell death. In the absence of dexamethasone, ∼40% cell death was seen at 2 to 3 days, whereas in its presence this value was ∼20% (Fig 3A legend). In sum, with short-term exposure to etoposide, Mcl-1 produced partial protection of cell viability, inhibiting cell death in a proportion of, but not the entire, cell population. Thus, the partial protection with progressive cell death observed previously (Fig 2A) is probably not simply a reflection of continuous drug exposure and the resultant cumulative death of cells with increasing levels of Mcl-1. Rather, partial protection may be an inherent property of Mcl-1 itself. Studies of CHO cells transfected with mcl-1 had yielded a similar conclusion.25
Effect of calcium ionophore on the viability on FDC-P1 transfectants expressing or not expressing mcl-1. (A) Photographs of clone 7.5-MAMmcl-1 either left untreated (Control) or exposed to 1.5 μmol/L A23187 in the absence (−Dex) or presence of dexamethasone (+Dex), as assessed by the ethidium bromide/acridine orange method. Arrows indicate cells that have condensed nuclei but have not lost membrane integrity. Photographs were taken at a magnification of 400×.
(B) Clones 7.5-MAMmcl-1 and 8.5-MAMneo were either incubated (+) or not incubated (−) with dexamethasone for 2 hours at an inoculum density of 5 × 105 cells/mL. A23187 (1.5 μmol/L) was added and cell viability was was assayed at the indicated times using the ethidium bromide/acridine orange method. The values shown are the mean ± SD of three independent experiments.
Effect of calcium ionophore on the viability on FDC-P1 transfectants expressing or not expressing mcl-1. (A) Photographs of clone 7.5-MAMmcl-1 either left untreated (Control) or exposed to 1.5 μmol/L A23187 in the absence (−Dex) or presence of dexamethasone (+Dex), as assessed by the ethidium bromide/acridine orange method. Arrows indicate cells that have condensed nuclei but have not lost membrane integrity. Photographs were taken at a magnification of 400×.
(B) Clones 7.5-MAMmcl-1 and 8.5-MAMneo were either incubated (+) or not incubated (−) with dexamethasone for 2 hours at an inoculum density of 5 × 105 cells/mL. A23187 (1.5 μmol/L) was added and cell viability was was assayed at the indicated times using the ethidium bromide/acridine orange method. The values shown are the mean ± SD of three independent experiments.
In the studies discussed above, expression of Mcl-1 had been induced before the addition of etoposide. We wished to determine whether prior induction was required and, if not, whether the induction of Mcl-1 could be delayed for an extended period of time after the addition of etoposide. To examine this question, we added dexamethasone either before or at various times after the addition of etoposide. We observed maximum enhancement of viability when dexamethasone was added before etoposide (Fig 3B). However, some effect was observed when dexamethasone was added up to 5 hours after etoposide. As the interval between the application of etoposide and dexamethasone was increased, the extent of enhancement of viability was decreased. The fact that maximum effectiveness was seen when dexamethasone was added at early times (Fig 3B) is probably related to the fact that etoposide can exert some effect after brief periods of drug exposure (Fig 3A). The fact that no effect was seen when dexamethasone was added more than 5 hours after etoposide may be related to the fact that DNA fragmentation becomes evident within about 5 to 7 hours after the application of etoposide to FDC-P1 cells (data not shown), similar to other systems.31,42,44 This suggests that, to be effective, Mcl-1 must be induced fairly early in etoposide-induced apoptosis, ideally before the onset of DNA fragmentation; this is in agreement with the results from morphologic assays described above suggesting an effect of Mcl-1 occurring earlier (phase I/II) rather than later (phase III) in the apoptotic process (see Fig 2 legend). As in other systems,25 we found the effects of Mcl-1, as assayed by DNA fragmentation gels, to be somewhat variable. This has been more extensively documented in CHO cells transfected with mcl-1, in which in some experiments protection of DNA fragmentation by Mcl-1 was near complete25 (Fig 2B), whereas in replicate experiments partial DNA fragmentation was seen. Partial DNA fragmentation in the presence of Mcl-1 as compared with more complete DNA fragmentation in its absence is particularly difficult to interpret, because the DNA fragmentation gel assay is nonquantitative. We note that, although DNA fragmentation into oligonucleosomes accompanies apoptosis in many cases, it does not define apoptosis, does not occur during apoptosis in some cells, and may even occur during necrosis.45,46 In review, in the experiments described here, we used the standard morphologic definition of apoptosis and found Mcl-1 to delay but not to prevent completely the induction of this process (Fig 2). Mcl-1 appeared to act in the initial rather than terminal phases of apoptosis (phase I/II as opposed to phase III; Fig 2 legend), and no effect was seen if induction of Mcl-1 was delayed until after the initiation of DNA digestion (ie, for >5 hours; Fig 3B). Overall, Mcl-1 appears to have effects similar to those of other viability enhancing members of the bcl-2 gene family, including Bcl-2 itself, Bcl-x, and BHFF1. These gene products can all delay cell death, although they do not completely block death for an indefinite period, and different Bcl-2 family members acting in different systems can have effects that are qualitatively similar but quantitatively different in the sense that death may be delayed for shorter or longer periods of time. The delay in cell death produced by Mcl-1 was such that, in transfectants induced to express Mcl-1, a doubling of the continuous exposure time to etoposide (Fig 2A) or an approximately fivefold increase in pulse etoposide exposure (Fig 3A) was required to produce as much cell death as in controls. The extent of this delay is within the range seen for other Bcl-2 family members.1,9,11,12,15-17,25,30,47 48
Delay of cell death in mcl-1 transfectants exposed to calcium ionophore or UV irradiation.Because of the broad range of the protective effects of Bcl-2,11,12,15,32,49 we wished to test the effects of Mcl-1 on cell death caused by agents other than etoposide. We exposed FDC-P1 transfectants to the calcium ionophore A23187, which had been reported to cause cell death by apoptosis.32,49,50 Indeed, upon exposure to A23187 in the absence of dexamethasone, the cell population contained cells in phase I/II of apoptosis (green staining cells with condensed nuclei; Fig 4A, middle photograph) as well as cells in phase III (orange staining cells with condensed nuclei). In the presence of dexamethasone, these dying cell populations were decreased (Fig 4A, right photograph). In sum, Mcl-1 delayed but did not completely prevent the death induced by A23187 (Fig 4B), mirroring the effects seen with etoposide. As a third cytotoxic agent, we exposed the transfectants to UV irradiation.12 33 We also observed here inhibition of cell death (Table 1). Overall, Mcl-1 was capable of enhancing viability in cells exposed to a variety of different types of cytotoxic stimuli.
Cell viability in transfectants exposed to growth factor deprivation.Bcl-2 can promote the viability of cells deprived of required growth factors,9,11,13 in addition to cells exposed to exogenous cytotoxic agents. We therefore wished to examine the effects of Mcl-1 in FDC-P1 transfectants deprived of the required growth factor IL-3. Unfortunately, we could not address this question clearly using the transfectants containing the inducible pMAMmcl-1 vector, because we found dexamethasone itself to be cytotoxic when applied in medium lacking growth factors, as noted in other systems.51 We thus performed an initial test comparing two clones that expressed Mcl-1 constitutively and two clones transfected with vector alone (S3- and S8-CMVmcl-1 v V1- and V2-CMVneo). Upon growth factor withdrawal, these four clones underwent growth-arrest and began to die (within ∼2 days; Fig 5). However, the two mcl-1 transfectants were observed to die at a slower rate than the two vector-only control clones (Fig 5). Expression of the introduced mcl-1 gene product was maintained in these experiments (Fig 1E, lanes 5 through 7), similar to the case of etoposide (Fig 1E, lanes 1 through 3). Continued expression of Mcl-1 was not unexpected because, although growth factor deprivation can cause a decrease in expression of the endogenous bcl-2 gene, it does not have this effect on exogenously introduced bcl-2,30,52,53 probably because exogenously introduced genes generally use heterologous promoters that are not susceptible to the same regulatory influences as the endogenous gene. In addition, we have not found growth factor deprivation to affect expression of the endogenous mcl-1 gene.29 Transfectants expressing Mcl-1 and deprived of growth factors exhibited ∼50% viability at 4 days, whereas nearly all control cells were dead at this time (<10% viable; Fig 5). Because control viability was ∼50% at 2 days, these findings were reminiscent of the findings with etoposide (Fig 2A) in which cultures expressing Mcl-1 required twice as much time as controls to sustain a similar level of cell death. Overall, observations in an initial four clones deprived of growth factors suggested that Mcl-1 caused an effect similar to that seen with cytotoxic agents.
Effect of growth/viability factor deprivation on FDC-P1 transfectants expressing versus not expressing mcl-1. mcl-1 transfectants (S3-CMVmcl-1 and S8-CMVmcl-1) and vector-only clones (V1-CMVneo and V2-CMVneo) were transferred from transfectant growth medium (containing 10% FBS and 10% WEHI-3b conditioned medium) to growth factor-depleted medium (containing 1% FBS and lacking a source of IL-3, see Materials and Methods) at an inoculum density of 5 × 105 cells/mL. Viability was assayed at the indicated times using trypan blue dye exclusion. The values shown are the mean ± SD of three independent experiments. The average total cell number (×105) in the mcl-1 transfectants was 6.7, 8.0, 7.9, and 7.6 on days 1 through 4, respectively. The average total cell number (×105) in the vector-only clones was 8.9, 9.5, 9.6, and 10.0 on days 1 through 4, respectively. Viability in growth factor-containing medium was greater than 96%.
Effect of growth/viability factor deprivation on FDC-P1 transfectants expressing versus not expressing mcl-1. mcl-1 transfectants (S3-CMVmcl-1 and S8-CMVmcl-1) and vector-only clones (V1-CMVneo and V2-CMVneo) were transferred from transfectant growth medium (containing 10% FBS and 10% WEHI-3b conditioned medium) to growth factor-depleted medium (containing 1% FBS and lacking a source of IL-3, see Materials and Methods) at an inoculum density of 5 × 105 cells/mL. Viability was assayed at the indicated times using trypan blue dye exclusion. The values shown are the mean ± SD of three independent experiments. The average total cell number (×105) in the mcl-1 transfectants was 6.7, 8.0, 7.9, and 7.6 on days 1 through 4, respectively. The average total cell number (×105) in the vector-only clones was 8.9, 9.5, 9.6, and 10.0 on days 1 through 4, respectively. Viability in growth factor-containing medium was greater than 96%.
For a more thorough assessment of the effects of Mcl-1 under conditions of growth factor deprivation, we tested a panel containing an additional four clones transfected with vector-alone and an additional five clones transfected with mcl-1, along with the four clones that had been used in the initial experiment above. Upon growth factor deprivation, three of the additional four vector-only clones exhibited less than 10% viable cells at 4 days, similar to what had been observed in the initial experiment (Table 2 and Fig 5). An unexpected finding was that clone V1-CMVneo exhibited less cell death than in the initial experiment (Table 2 and Fig 5). In addition, clone V5-CMVneo exhibited little cell death; this clone was not completely factor-independent in that proliferation abated upon growth factor withdrawal (Table 2, second column note) despite the minimal loss of viability. This sporadic appearance of viability factor independence may relate to the fact that FDC-P1 cells were somewhat difficult to transfect (see Materials and Methods) and underwent multiple generations of clonal outgrowth before they could be tested for viability. Thus, some aspect of the process of electroporation/G-418 selection/clonal expansion may have exerted selection pressure for the outgrowth of occasional FDC-P1 clones that were factor-independent for viability. Overall, vector-only FDC-P1 clones were capable of becoming factor-independent in terms of viability (but not proliferation), although the majority of clones remained completely factor-dependent.
Among the clones transfected with mcl-1, the majority expressed readily detectable levels of Mcl-1, whereas a few exhibited only faintly detectable levels of the protein. Upon growth factor deprivation, the transfectants expressing readily detectable Mcl-1 exhibited 43% to 50% viability at 4 days (Table 2), similar to the results from the initial experiment (Fig 5). Clones expressing only faintly detectable Mcl-1 exhibited lower viability (18% to 26%), with one exception that was similar to the exceptional vector-only V5-CMVneo clone in that it exhibited very little cell death (Table 2, ‡ note). Overall, clones transfected with mcl-1 appeared to exhibit enhanced viability under conditions of growth factor deprivation. All of the clones expressing readily detectable Mcl-1 exhibited ∼50% viability at 4 days. In contrast, the majority of clones transfected with vector-alone exhibited near-complete cell death at this time, although occasional clones were capable of converting to viability factor independence.
DISCUSSION
In the work described here, we set out to address the question of whether Mcl-1 could have effects on the viability of hematopoietic FDC-P1 cells. We wished to test these effects under a variety of different cytotoxic conditions, particularly conditions that had not been tested previously with Mcl-1 such as exposure to exogenously applied cytotoxic drugs or UV radiation. We performed extensive studies with the cytotoxic drug etoposide using a transfectant that expressed Mcl-1 on an inducible basis. We found that even a 0.5-hour pulse of exposure to this drug resulted in the subsequent loss of a considerable portion of the cell population in the absence of induction of Mcl-1; however, with induction of Mcl-1, about one half of the cell population that would otherwise have died remained viable. Increasing the duration of drug exposure resulted in increasing cell death; however, the difference between control and mcl-1–transfected cells was maintained, with an ∼10-fold increase in drug concentration (or an ∼5-fold increase in the duration of exposure) being required to cause viability in the presence of Mcl-1 to decrease to control levels. Enhancement of viability was even seen upon continuous exposure to etoposide, with mcl-1 transfectants requiring twice as much time as controls to decrease to an equivalent level of viability, although the majority of transfectants eventually did die (within ∼3 days). Similar effects have been seen in other systems with Bcl-2 and Bcl-x.47,54,55 For example, in another murine hematopoietic cell line (BAF3) transfected with bcl-2, the time course of effects of continuous exposure to etoposide is quite similar to the time course we observed in FDC-P1 cells with mcl-1 (approximately equivalent cell viability at 1.5 and 1 days with and without Bcl-2, respectively).47 In FDC-P1 cells, we also observed Mcl-1 to promote viability upon exposure to calcium ionophore or UV radiation, as has been observed with Bcl-2.16,32 48 In agreement with the fact that Mcl-1 had effects on viability similar to those of Bcl-2, we also found Mcl-1 to be capable of associating with Bax as can Bcl-2.
Although Mcl-1 decreased the percentage of FDC-P1 cells that died, it did not decrease the relative proportions of dead cells in phases I/II of apoptosis (nuclear condensation/fragmentation without loss of membrane integrity) versus phase III (secondary loss of membrane integrity). One possible explanation for this finding is that Mcl-1 slows the entry of cells into phase I/II of apoptosis, but that, once this process is initiated, mcl-1 does not affect the progression to phase III. An effect of mcl-1 in the earlier phases of apoptosis was also suggested by experiments in which expression of Mcl-1 was induced by dexamethasone at different times relative to the addition of etoposide. It was found here that early addition of dexamethasone (ideally before etoposide) had a greater protective effect than later addition of the inducer. Addition of dexamethasone at time points of more than 5 hours resulted in no protective effect. Bcl-2 has similarly been suggested to act during the early stages of etoposide-induced apoptosis.11 Overall, the above results show similarities between Mcl-1 and Bcl-2 in that Mcl-1 affords protection of viability to FDC-P1 cells exposed to a variety of exogenously applied cytotoxic agents, exerting its effects at an early phase of apoptosis.
In addition to testing the effects of Mcl-1 in transfectants exposed to exogenously applied cytotoxic agents, we also investigated the effects of the gene in transfectants deprived of required growth factors. For these experiments, we did not use clones transfected with the dexamethasone-inducible mcl-1 vector, because we found dexamethasone itself to be toxic under conditions of growth factor deprivation. We thus examined a panel of transfectants constitutively expressing Mcl-1 and vector-only controls. Examination of this panel unexpectedly showed that a minority of FDC-P1 clones, even clones transfected with vector alone, can convert to factor-independence for viability while remaining factor-dependent for proliferation. These infrequent clones were somewhat different from those reported by other investigators, who have found that FDC-P1 and similar cells are capable of converting to complete factor independence, ie, to survival and proliferation in the absence of growth factors.56-60 Our finding of factor-independent cell survival without proliferation probably reflects the fact that growth factors may trigger two separate signal transduction pathways, one involved in the maintenance of viability and another involved in the stimulation of proliferation.13,61 62 The sporadic viability factor-independent, proliferation factor-dependent FDC-P1 cell clones may have alterations in the former, but not the latter, of these pathways.
In view of the sporadic conversion of FDC-P1 cells to viability factor independence, it is necessary to exert caution in interpreting the enhanced survival of mcl-1 transfectants under conditions of growth factor deprivation. Our results lend themselves to two possible interpretations. One possible interpretation is that Mcl-1 can provide protection when FDC-P1 cells are deprived of growth factors, as when cells are exposed to exogenous cytotoxic agents. A second possible interpretation is that Mcl-1 might enhance the low endogenous possibility of conversion to viability factor independence. The present data cannot clearly distinguish among these or other possibilities. However, we observed that all transfectants expressing readily detectable levels of Mcl-1, as opposed to only occasional controls, exhibited enhanced viability upon growth factor withdrawal. In addition, the sporadic conversion seen in controls had the capacity of producing near-complete protection from growth factor deprivation, whereas mcl-1 transfectants exhibited partial protection. These observations make the second possibility, that Mcl-1 enhances an endogenous tendency, seem less likely. We thus hypothesize that the viability of FDC-P1 clones deprived of growth factors could be influenced by two events, one being transfection with mcl-1 and another being a spontaneous event that remains to be characterized.
Taken as a whole, the results described above show that Mcl-1 can promote cell viability without promoting cell growth under a variety of conditions that produce cell death by apoptosis. In this respect, mcl-1 is similar to other members of the bcl-2 gene family. We note that, in some systems, Bcl-2 can inhibit cell proliferation, in addition to enhancing cell viability.20 In addition, although Bcl-2 may allow cells to survive longer, the cells that survive may not retain proliferative capacity in that they may not have the ability to regrow as colonies.63 We have recently shown in the CHO system that even in cells in which Bcl-2 allows a modest amount of regrowth, suppression of regrowth by Mcl-1 remains strong.25 64 Overall, various members of the Bcl-2 family, including Mcl-1, can preserve cell viability without necessarily preserving cell proliferative capacity. In the case of Mcl-1, this is in accord with the fact that Mcl-1 expression is dramatically increased during the induction of differentiation, which is accompanied by an irreversible loss of the ability to proliferate.
Our results with FDC-P1 cells contrast with a previous report showing a lack of effect of Mcl-1 (but not Bcl-2) in 32D cells.27 Several factors may contribute to the differences between the present report versus the previous report, including the difference in cell lines, possibly differences in levels of the transfected mcl-1 gene product, and differences in its association with Bax. We cannot compare the Mcl-1 levels we obtained in FDC-P1 cells with those present in the published 32D transfectants; this could be a factor, because we were unable to achieve levels in 32D as high as those achieved in FDC-P1. In addition to the question of levels, we observed an association between Mcl-1 and Bax in FDC-P1, in contrast to the lack of association reported for 32D. Because the association of Bcl-2 with Bax is thought to be important for viability enhancement,23,24 the difference in association of Mcl-1 with Bax in FDC-P1 versus 32D is likely to be an important factor in the differences in protective effects seen in these two cell lines. We are currently testing the effects of Mcl-1 in additional cell types, and preliminary results suggest that, in other hematopoietic cells, Mcl-1 can have effects similar to those observed here in FDC-P1.65 These findings show that Mcl-1 is indeed capable of interacting with Bax and enhancing the viability of hematopoietic cells; they thus provide further parallels between Mcl-1 and Bcl-2.
The reason we chose a murine cell line (FDC-P1) for this work was that we were unable to achieve stable transfection in the human hematopoietic ML-1 cell line from which mcl-1 was isolated. In ML-1 cells, expression of Mcl-1 increases rapidly in the early stages of differentiation.3,5,29 In view of the fact that differentiation in ML-1 is induced by a potentially cytotoxic agent (TPA), this pattern of expression prompts one to ask whether the endogenous gene in ML-1 cells might have effects similar to those seen with exogenous introduction into FDC-P1. For example, Mcl-1 might be speculated to function as follows. As immature, proliferative hematopoietic cells are induced to exit the cell cycle and initiate differentiation, they may have the possibility of undergoing cell death as an alternative fate. An increase in the expression of Mcl-1 might serve as a means of preventing these cells from entering the pathway towards death, thereby allowing them to follow the pathway towards differentiation. In other words, the increase in Mcl-1 seen during the initiation of differentiation3,29 might aid in the maintenance of cell viability during the switch from proliferating to differentiating phenotype. Bcl-2 has similarly been shown to allow FDCP-Mix cells to survive and further differentiate under conditions that normally promote death,66 and Bcl-2 can promote the survival and partial maturation of T cells67 and B cells.68 Taken together, these findings suggest that Mcl-1, Bcl-2, and possibly other members of this family might exert their functions at important viability control points along the pathway of differentiation.
ACKNOWLEDGMENT
We thank Dr B. Vogelstein for providing the CMVneoBam vector and are grateful to Dr W.S. May, Dr R. Jones, and Dr A. Friedman for their help and advice in working with murine hematopoietic cell lines. We also thank Dr A. Eastman, Dr W.S. May, and Dr C. Cole for reviewing the manuscript.
Supported by a grant from the National Cancer Institute (CA57359).
Address reprint requests to Ruth W. Craig, PhD, Dartmouth-Hitchcock Medical Center, Dartmouth Medical School, Department of Pharmacology and Toxicology, 7650 Remsen, Hanover, NH 03755-3835.


![Fig. 1. Expression of the introduced mcl-1 gene product in FDC-P1 transfectants. FDC-P1 clones transfected with either the inducible pMAMmcl-1 vector (A and C), the constitutively expressing pCMVmcl-1 vector (B and D), or appropriate control vectors (no mcl-1 insert) were assayed for expression of the introduced Mcl-1 gene product (A, B, and D) or expression of bcl-2 (B) by Western blot. (A) mcl-1 transfectant 7.5-MAMmcl-1 (lanes 1 through 4) and vector-only clone 8.5-MAMneo (lanes 5 and 6) were either exposed (+) or not exposed (−) to dexamethasone and assayed at 2 hours. Lysate from TPA-induced ML-1 cells (5 × 10−10 mol/L TPA for 3 hours) was included on the blot for comparative purposes (lane 7). Each lane contains 40 μg of protein. Either preimmune serum (lane 1, Pre.) or anti–mcl-1 immune serum (affinity-purified, lanes 2 through 7) was used. In lane 3, the immune serum had been blocked (Bl.) with bacterially produced mcl-1–GST fusion protein. (B) mcl-1 transfectants S3-CMVmcl-1 and S8-CMVmcl-1 and vector-only clones V1-CMVneo and V2-CMVneo were assayed for expression of Mcl-1 as in (A), except that an IgG fraction of the anti–mcl-1 antiserum was used. The lysate in lanes 1 through 4 represents 2 × 106 cell equivalents and that in lane 5 represents 2 × 105 cell equivalents. The numbers on the left indicate molecular weight markers (in kilodaltons). (C) The transfectant clones shown in (A) were assayed for expression of the endogenous mouse bcl-2 gene produce. Each lane represent 1 × 106 cell equivalents. (D) The S3-CMVmcl-1 transfectant was used for immunoprecipitation of either mcl-1 (lanes 1 and 4; 8 × 106 cell equivalents per lane) or bcl-2 (lane 2). Lane 3 contains lysate (no immunoprecipitation) from TPA-treated ML-1 cells (106 cells as in [A], lane 7), which had previously been found to express abundant levels of Bax. After immunoprecipitation, Western blotting was performed using an anti-bax antibody (lanes 1 through 3) or the anti-bax antibody after preincubation with the peptide against which the antibody had been generated. (E) The transfectant clones shown in (B) were assayed for expression of the introduced Mcl-1 gene product after exposure for 1 day to 20 μg/mL etoposide (lanes 1 through 3) or after incubation for 3 days to medium lacking IL-3 and FBS (lanes 5 through 7). The number of cell equivalents loaded was 4 × 106 in lanes 1 through 3 and 2 × 106 in lanes 5 through 7. ML-1 cells treated with TPA (5 × 10−10 mol/L for 3 hours) were included on the blot as a positive control (2 × 105 cell equivalents; lanes 4 and 8).](https://ash.silverchair-cdn.com/ash/content_public/journal/blood/89/2/10.1182_blood.v89.2.630/4/m_bl_0013f1.jpeg?Expires=1769095529&Signature=DeuCkt4wJbSNguxAJLhIIPHHkiuwNGJpDfF0wM6reQTRhi93MDBwuKKo8cDurMDefhjwRzcCtImY2jPb8TpBDJUdgGiljTcJW2eHMlyc0f2dz9ux7LpcepRKflPZ5SurV0JxNZbn25AgycXUe3QM3kqYzhNIHa21tjGxnvvu4pLjyU38huPRHl87fVmKkiHu8hZFd27MVZ1vqnZS0fiTYJ1WvWdtl6h24OhUtpzlbz1Hxmpjs~kFUSXVG-fOid5AQJAGy4WPUC44TttoqW-mSqm5upGKzZq~e9~3YYKhjeq1UaXT2nIm4XUjD~N2wMJiqT7-lB-ChsXDccHs5UgTzQ__&Key-Pair-Id=APKAIE5G5CRDK6RD3PGA)
![Fig. 2. Effect of etoposide on the viability of FDC-P1 transfectants expressing or not expressing mcl-1. (A) Effect of continuous exposure to etoposide for increasing times. The 7.5-MAMmcl-1 transfectant (circles) and the 8.5-MAMneo vector-only clone (squares) were either exposed (solid symbols) or not exposed (open symbols) to dexamethasone for 2 hours at an inoculum density of 6 × 105 cells/mL. Etoposide was then applied at 20 μg/mL (time 0). Cell viability was assayed at 1, 2, and 3 days using the ethidium bromide/acridine orange method. This experiment was also performed with clones expressing mcl-1 constitutively. When clones S3- and S8-CMVmcl-1 were exposed to etoposide for 1 day, cell viability was 73% ± 14% (SD; n = 3 independent experiments) and 62% ± 13%, respectively, compared with a value of 37% ± 12% in vector-only clone V5-CMVneo. Upon exposure for 2 days, these values were 43% ± 15%, 33% ± 12%, and 17% ± 6% for S3-CMVmcl-1, S8-CMVmcl-1, and V5-CMVneo, respectively, and with exposure for 3 days the values were 29% ± 6%, 31% ± 10%, and 12% ± 3%. (B) Effect of various concentrations of etoposide. Cells were treated as in (A), except that various concentrations of etoposide were applied for 1 day. Of the nonviable cells in cultures treated for with 20 μg/mL etoposide, the fraction of cells in phases I or II of apoptosis (as a percentage of the total dead cells) was 72% ± 9.8% and 73% ± 9.7% in clone 7.5-MAMmcl-1 in the absence and presence of dexamethasone, respectively (n = 6, 3 values from the experiments shown in [A] and 3 values from the experiments shown in [B]). These values were 62% ± 5.7% and 63% ± 9.3% for clone 8.5-MAMneo in the absence and presence of dexamethasone, respectively. For both (A) and (B), the values shown are the mean ± SD of three independent experiments. / (C) Illustration of the effects of etoposide. The vector-only 8.5-MAMneo clone (left photograph) and the 7.5MAMmcl-1 transfectant (right photograph) were exposed to dexamethasone and etoposide as in (A). Cells were stained after 1 day with DAPI. The vector-only clone contains cells with condensing or fragmenting nuclei, whereas the mcl-1 transfectant contains cells with the open/lacy nuclear architecture and staining pattern typical of viable control cells. Photographs were taken at a magnification of 1,250×.](https://ash.silverchair-cdn.com/ash/content_public/journal/blood/89/2/10.1182_blood.v89.2.630/4/m_bl_0013f2c.jpeg?Expires=1769095529&Signature=QeHY3pkvYQeseTtteeIsMIran3ep1DrWd7i7i0MwYa0PktXNBZtVKMUiocNWYbn6LV9UVmm65b7v6fH6f6raODpHR2h53v7V3s3nyD~JvIEFj2B0xweOGQTR-EJ2FpSKtmvw7sYmvgSUwl~0roONIwfW5P8m0vuZ5iJwgGR8Yw8jnClz3jTVtOTqqX8Gwz4X4XooOjR30H7tL1NKzENOlhLWZA5NRfvztkK6~tTQrvVrTYJ-bSeE65Z967SqhtEcRViJCAxzeMEzsn3QWnl7qCT3D5cgH5Le45ryPEF7AX22akb-8traz3GFWi0TBfQlb32ZrXDXdYmhZiDWQPtLbw__&Key-Pair-Id=APKAIE5G5CRDK6RD3PGA)